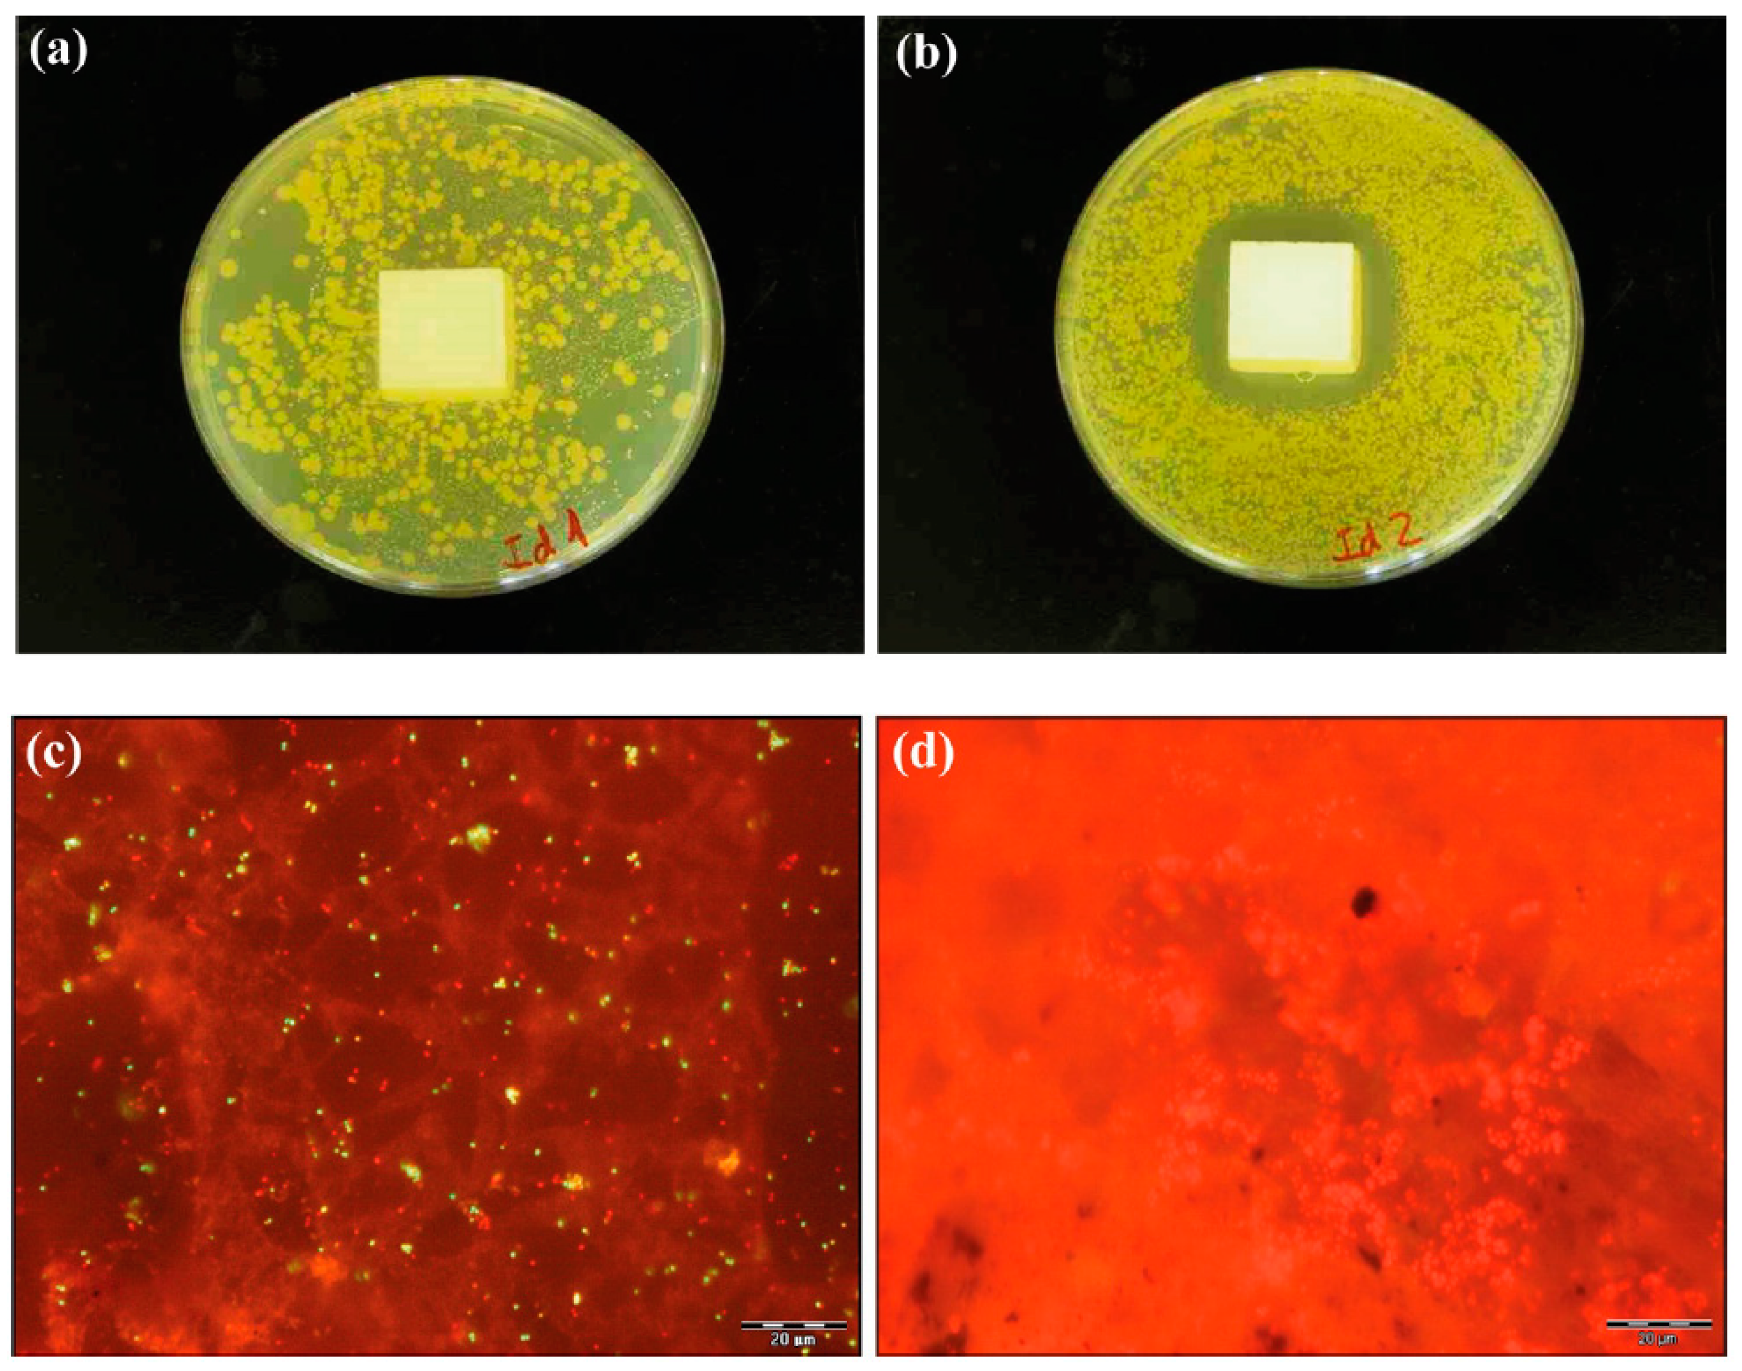
Applsci 09 01717 g001

The Effects of Dry, Humid and Wear Conditions on the Antimicrobial Efficiency of Triclosan-Containing Surfaces
Abstract
:Featured Application
Abstract
1. Introduction
2. Materials and Methods
2.1. Bacterial Strain and Test Surfaces
2.2. Interfering Substance, Neutralizing Medium and Test Diluent
2.3. Procedure to Test the Antimicrobial Activity
2.4. Procedure to Test the Bacterial Inhibition Under Dry, Humid and Wear Conditions
2.5. Microscopy
2.6. Assessing the Antimicrobial Activity and the Bacterial Inhibition
2.7. Statistical Analysis
3. Results and Discussion
4. Conclusions
Author Contributions
Funding
Acknowledgments
Conflicts of Interest
References
- Grunert, K.G. Food quality and safety: Consumer perception and demand. Eur. Rev. Agric. Econ. 2005, 32, 369–391. [Google Scholar] [CrossRef]
- Havelaar, A.H.; Brul, S.; de Jong, A.; de Jonge, R.; Zwietering, M.H.; ter Kuile, B.H. Future challenges to microbial food safety. Int. J. Food Microbiol. 2010, 139, S79–S94. Available online: https://www.sciencedirect.com/science/article/pii/S0168160509005376 (accessed on 26 January 2019).
- World Health Organization (WHO). WHO Estimates of the Global Burden of Foodborne Diseases: Foodborne Disease Burden Epidemiology Reference Group 2007–2015; WHO Library Cataloguing-In-Publication Data: Geneva, Switzerland, 2015; 268p, Available online: https://apps.who.int/iris/handle/10665/199350 (accessed on 26 January 2019).
- Simões, M.; Simões, L.C.; Vieira, M.J. A review of current and emergent biofilm control strategies. LWT Food Sci. Technol. 2010, 43, 573–583. Available online: https://www.sciencedirect.com/science/article/pii/S0023643809003430 (accessed on 26 January 2019). [CrossRef]
- Satpathy, S.; Sen, S.K.; Pattanaik, S.; Raut, S. Review on bacterial biofilm: An universal cause of contamination. Biocatal. Agric. Biotechnol. 2016, 7, 56–66. Available online: https://www.sciencedirect.com/science/article/pii/S1878818116300937 (accessed on 26 January 2019). [CrossRef]
- González-Rivas, F.; Ripolles-Avila, C.; Fontecha-Umaña, F.; Ríos-Castillo, A.G.; Rodríguez-Jerez, J.J. Biofilms in the spotlight: Detection, quantification, and removal methods. Compr. Rev. Food Sci. Food Saf. 2018, 17, 1261–1276. Available online: https://onlinelibrary.wiley.com/doi/10.1111/1541-4337.12378 (accessed on 26 January 2019). [CrossRef]
- Kusumaningrum, H.D.; Riboldi, G.; Hazeleger, W.C.; Beumer, R.R. Survival of foodborne pathogens on stainless steel surfaces and cross-contamination to foods. Int. J. Food Microbiol. 2003, 85, 227–236. Available online: https://www.sciencedirect.com/science/article/pii/S0168160502005408 (accessed on 26 January 2019). [CrossRef]
- Nerín, C.; Aznar, M.; Carrizo, D. Food contamination during food process. Trends Food Sci. Technol. 2016, 48, 63–68. Available online: https://www.sciencedirect.com/science/article/abs/pii/S0924224415301370 (accessed on 26 January 2019). [CrossRef]
- Ripolles-Avila, C.; Ríos-Castillo, A.G.; Rodríguez-Jerez, J.J. Development of a peroxide biodetector for a direct detection of biofilms produced by catalase-positive bacteria on food-contact surfaces. CYTA J. Food 2018, 16, 506–515. Available online: https://www.tandfonline.com/doi/abs/10.1080/19476337.2017.1418434 (accessed on 26 January 2019).
- Zottola, E.A.; Sasahara, K.C. Microbial biofilms in the food processing industry—Should they be a concern? Int. J. Food Microbiol. 1994, 23, 125–148. Available online: https://www.sciencedirect.com/science/article/pii/0168160594900477 (accessed on 26 January 2019). [CrossRef]
- Srey, S.; Jahid, I.K.; Ha, S.-D. Biofilm formation in food industries: A food safety concern. Food Control 2013, 31, 572–585. Available online: https://www.sciencedirect.com/science/article/pii/S0956713512006536 (accessed on 26 January 2019). [CrossRef]
- Scott, E.; Bloomfield, S.F.; Barlow, C.G. Evaluation of disinfectants in the domestic environment under “in use” conditions. J. Hyg. 1984, 92, 193–203. Available online: https://www.ncbi.nlm.nih.gov/pmc/articles/PMC2129245/ (accessed on 26 January 2019). [CrossRef]
- Cozad, A.; Jones, R.D. Disinfection and the prevention of infectious disease. Am. J. Infect. Control 2003, 31, 243–254. Available online: https://www.ncbi.nlm.nih.gov/pubmed/12806363 (accessed on 26 January 2019). [CrossRef]
- Reij, M.W.; Den Aantrekker, E.D. Recontamination as a source of pathogens in processed foods. Int. J. Food Microbiol. 2004, 91, 1–11. Available online: https://www.sciencedirect.com/science/article/pii/S0168160503002952 (accessed on 26 January 2019). [CrossRef]
- Lee, D.G.; Zhao, F.; Rezenom, Y.H.; Russell, D.H.; Chu, K.-H. Biodegradation of triclosan by a wastewater microorganism. Water Res. 2012, 46, 4226–4234. Available online: https://www.ncbi.nlm.nih.gov/pubmed/22673343 (accessed on 26 January 2019). [CrossRef] [PubMed]
- Walters, G.I.; Robertson, A.S.; Moore, V.C.; Burge, P.S. Occupational asthma caused by sensitization to a cleaning product containing triclosan. Ann. Allergy Asthma Immunol. 2017, 118, 370–371. Available online: https://www.annallergy.org/article/S1081-1206(16)31364-3/abstract (accessed on 26 January 2019). [CrossRef]
- Guo, J.; Iwata, H. Risk assessment of triclosan in the global environment using a probabilistic approach. Ecotoxicol. Environ. Saf. 2017, 143, 111–119. Available online: https://www.ncbi.nlm.nih.gov/pubmed/28525814 (accessed on 26 January 2019). [CrossRef] [PubMed]
- Møretrø, T.; Sonerud, T.; Mangelrød, E.; Langsrud, S. Evaluation of the antibacterial effect of a triclosan-containing floor used in the food industry. J. Food Prot. 2006, 69, 627–633. Available online: https://www.ncbi.nlm.nih.gov/pubmed/16541695 (accessed on 26 January 2019). [CrossRef]
- Espitia, P.; Batista, R.; Otoni, C.; Soares, N. Antimicrobial food packaging incorporated with triclosan. In Antimicrobial Food Packaging; Barros-Velázquez, J., Ed.; Academic Press: London, UK, 2016; pp. 417–423. [Google Scholar]
- Scientific Committee on Consumer Safety (SCCS). Opinion on Triclosan, Antimicrobial Resistance. 2010. Available online: https://ec.europa.eu/health/scientific_committees/consumer_safety/docs/sccs_o_023.pdf (accessed on 22 January 2019).
- Rodricks, J.V.; Swenberg, J.A.; Borzelleca, J.F.; Maronpot, R.R.; Shipp, A.M. Triclosan: A critical review of the experimental data and development of margins of safety for consumer products. Crit. Rev. Toxicol. 2010, 40, 422–484. Available online: https://www.ncbi.nlm.nih.gov/pubmed/20377306 (accessed on 26 January 2019). [CrossRef] [PubMed]
- Fang, J.-L.; Stingley, R.L.; Beland, F.A.; Harrouk, W.; Lumpkins, D.L.; Howard, P. Occurrence, efficacy, metabolism, and toxicity of triclosan. J. Environ. Sci. Health Part C Environ. Carcinog. Ecotoxicol. Rev. 2010, 28, 147–171. Available online: https://www.ncbi.nlm.nih.gov/pubmed/20859822 (accessed on 26 January 2019). [CrossRef]
- Ruszkiewicz, J.A.; Li, S.; Rodriguez, M.B.; Aschner, M. Is triclosan a neurotoxic agent? J. Toxicol. Environ. Health B Crit. Rev. 2017, 20, 104–117. Available online: https://www.ncbi.nlm.nih.gov/pubmed/28339349 (accessed on 26 January 2019). [CrossRef]
- Weatherly, L.M.; Gosse, J.A. Triclosan exposure, transformation, and human health effects. J. Toxicol. Environ. Health B Crit. Rev. 2017, 20, 447–469. Available online: https://www.ncbi.nlm.nih.gov/pubmed/29182464 (accessed on 26 January 2019). [CrossRef]
- Petersen, R.C. Triclosan antimicrobial polymers. AIMS Mol. Sci. 2016, 3, 88–103. Available online: https://www.ncbi.nlm.nih.gov/pmc/articles/PMC4893770/ (accessed on 26 January 2019). [CrossRef]
- Cloete, T.E. Resistance mechanisms of bacteria to antimicrobial compounds. Int. Biodeterior. Biodegradation. 2003, 51, 277–282. Available online: https://www.sciencedirect.com/science/article/pii/S0964830503000428 (accessed on 26 January 2019). [CrossRef]
- Russell, A.D. Whither triclosan? J. Antimicrob. Chemother. 2004, 53, 693–695. Available online: https://www.ncbi.nlm.nih.gov/pubmed/15073159 (accessed on 26 January 2019). [CrossRef]
- Yazdankhah, S.P.; Scheie, A.A.; Høiby, E.A.; Lunestad, B.T.; Heir, E.; Fotland, T.Ø.; Naterstad, K.; Kruse, H. Triclosan and antimicrobial resistance in bacteria: An overview. Microb. Drug Resist. 2006, 12, 83–90. Available online: https://www.ncbi.nlm.nih.gov/pubmed/16922622 (accessed on 26 January 2019). [CrossRef]
- Kim, C.Y.; Ryu, G.J.; Park, H.Y.; Ryu, K. Resistance of Staphylococcus aureus on food contact surfaces with different surface characteristics to chemical sanitizers. J. Food Saf. 2017, 37, e12354. Available online: https://onlinelibrary.wiley.com/doi/abs/10.1111/jfs.12354 (accessed on 26 January 2019). [CrossRef]
- Grace, D.; Fetsch, A. Staphylococcus aureus—A foodborne pathogen: Epidemiology, detection, characterization, prevention, and control: An overview. In Staphylococcus Aureus; Fetsch, A., Ed.; Academic Press: London, UK, 2018; pp. 3–10. [Google Scholar]
- Castro, A.; Silva, J.; Teixeira, P. Staphylococcus aureus, a food pathogen: Virulence factors and antibiotic resistance. In Foodborne Diseases; Holban, A., Grumezescu, A., Eds.; Academic Press: London, UK, 2018; pp. 213–238. [Google Scholar]
- Götz, F. Staphylococcus and biofilms. Mol. Microbiol. 2002, 43, 1367–1378. Available online: https://www.ncbi.nlm.nih.gov/pubmed/11952892 (accessed on 26 January 2019). [CrossRef]
- Rode, T.M.; Langsrud, S.; Holck, A.; Møretrø, T. Different patterns of biofilm formation in Staphylococcus aureus under food-related stress conditions. Int. J. Food Microbiol. 2007, 116, 372–383. Available online: https://www.sciencedirect.com/science/article/pii/S0168160507001626 (accessed on 26 January 2019). [CrossRef]
- Archer, N.K.; Mazaitis, M.J.; Costerton, J.W.; Leid, J.G.; Powers, M.E.; Shirtliff, M.E. Staphylococcus aureus biofilms. Virulence 2011, 2, 445–459. Available online: https://www.ncbi.nlm.nih.gov/pmc/articles/PMC3322633/ (accessed on 26 January 2019). [CrossRef]
- Gervilla, R.; Ferragut, V.; Guamis, B. High pressure inactivation of microorganisms inoculated into ovine milk of different fat contents. J. Dairy Sci. 2000, 83, 674–682. Available online: https://www.sciencedirect.com/science/article/pii/S0022030200749289 (accessed on 26 January 2019). [CrossRef]
- Briñez, W.J.; Roig-Sagués, A.X.; Hernández-Herrero, M.M.; López-Pedemonte, T.; Guamis, B. Bactericidal efficacy of peracetic acid in combination with hydrogen peroxide against pathogenic and non pathogenic strains of Staphylococcus spp., Listeria spp. and Escherichia coli. Food Control 2006, 17, 516–521. Available online: https://www.sciencedirect.com/science/article/pii/S0956713505000630 (accessed on 26 January 2019). [CrossRef]
- Ríos-Castillo, A.G.; Fontecha-Umaña, F.F.; Rodríguez-Jerez, J.J. Long-term antibacterial efficacy of disinfectants based on benzalkonium chloride and sodium hypochlorite tested on surfaces against resistant gram-positive bacteria. Food Control 2018, 93, 219–225. Available online: https://www.sciencedirect.com/science/article/pii/S0956713505000630 (accessed on 27 January 2019).
- Lowy, F.D. Antimicrobial resistance: The example of Staphylococcus aureus. J. Clin. Investig. 2003, 111, 1265–1273. Available online: https://www.jci.org/articles/view/18535 (accessed on 27 January 2019). [CrossRef]
- Monaco, M.; Pimentel de Araujo, F.; Cruciani, M.; Coccia, E.M.; Pantosti, A. Worldwide epidemiology and antibiotic resistance of staphylococcus aureus. In Staphylococcus Aureus; Springer: Cham, Switzerland, 2016; Volume 409, pp. 21–56. Available online: https://link.springer.com/chapter/10.1007%2F82_2016_3 (accessed on 27 January 2019).
- Feßler, A.T.; Li, J.; Kadlec, K.; Wang, Y.; Schwarz, S. Antimicrobial resistance properties of Staphylococcus aureus. In Staphylococcus Aureus; Fetsch, A., Ed.; Academic Press: London, UK, 2018; pp. 57–85. [Google Scholar]
- Anonymous. Chemical Disinfectants and Antiseptics. Quantitative Non-Porous Surface Test for the Evaluation of Bactericidal and/or Fungicidal Activity of Chemical Disinfectants Used In Food, Industrial, Domestic and Institutional Areas. Test Method and Requirements without Mechanical Action (Phase 2, Step 2); European Standard: London, UK, 2015; 36p, EN 13697:2015. [Google Scholar]
- International Organization for Standardization (ISO). ISO 22196:2011. Measurement of Antibacterial Activity on Plastics and Other Non-Porous Surfaces; ISO: Geneva, Switzerland, 2011. [Google Scholar]
- Ríos-Castillo, A.G.; Thompson, K.D.; Adams, A.; Marín de Mateo, M.; Rodríguez-Jerez, J.J. Biofilm formation of Flavobacterium psychrophilum on various substrates. Aquacult. Res. 2018, 49, 3830–3837. Available online: https://onlinelibrary.wiley.com/doi/abs/10.1111/are.13849 (accessed on 27 January 2019).
- Cutter, C.N. The effectiveness of triclosan incorporated plastic against bacteria on beef surfaces. J. Food Prot. 1999, 62, 474–479. Available online: https://www.ncbi.nlm.nih.gov/pubmed/10340667 (accessed on 8 March 2019). [CrossRef]
- Junker, L.M.; Hay, A.G. Effects of triclosan incorporation into ABS plastic on biofilm communities. J. Antimicrob. Chemother. 2004, 53, 989–996. Available online: https://www.ncbi.nlm.nih.gov/pubmed/15117930 (accessed on 8 March 2019). [CrossRef]
- Møretrø, T.; Høiby-Pettersen, G.S.; Habimana, O.; Heir, E.; Langsrud, S. Assessment of the antibacterial activity of a triclosan-containing cutting board. Int. J. Food Microbiol. 2011, 146, 157–162. Available online: https://www.sciencedirect.com/science/article/pii/S0168160511000961?via%3Dihub (accessed on 27 January 2019). [CrossRef]
- McEldowney, S.; Fletcher, M. The effect of temperature and relative humidity on the survival of bacteria attached to dry solid surfaces. Lett. Appl. Microbiol. 1988, 7, 83–86. Available online: https://onlinelibrary.wiley.com/doi/abs/10.1111/j.1472-765X.1988.tb01258.x (accessed on 27 January 2019). [CrossRef]
- Robine, E.; Boulangé-Petermann, L.; Derangère, D. Assessing bactericidal properties of materials: The case of metallic surfaces in contact with air. J. Microbiol. Methods 2002, 49, 225–234. Available online: https://www.sciencedirect.com/science/article/pii/S0167701201003712 (accessed on 27 January 2019). [CrossRef]
- Chmielewski, R.A.N.; Frank, J.F. Biofilm formation and control in food processing facilities. Compr. Rev. Food Sci. Food Saf. 2003, 2, 22–32. Available online: https://onlinelibrary.wiley.com/doi/abs/10.1111/j.1541-4337.2003.tb00012.x (accessed on 27 January 2019). [CrossRef]
- Bloomfield, S.F.; Arthur, M.; Begun, K.; Patel, H. Comparative testing of disinfectants using proposed European surface test methods. Lett. Appl. Microbiol. 1993, 17, 119–125. Available online: https://onlinelibrary.wiley.com/doi/abs/10.1111/j.1472-765X.1993.tb01439.x (accessed on 27 January 2019). [CrossRef]
- Hunsinger, B.; Abele, A.; Böhm, R. Effects of the drying conditions on different Gram negative bacteria on stainless steel discs used in the “quantitative surface test for the evaluation of bactericidal activity of chemical disinfectants” (EN 14349). In Proceedings of the XIIth International Congress in Animal Hygiene (ISAH 2005), Warsaw, Poland, 4–8 September 2005. [Google Scholar]
- Ripolles-Avila, C.; Hascoët, A.S.; Guerrero-Navarro, A.E.; Rodríguez-Jerez, J.J. Establishment of incubation conditions to optimize the in vitro formation of mature Listeria monocytogenes biofilms on food-contact surfaces. Food Control 2018, 92, 240–248. Available online: https://www.sciencedirect.com/science/article/pii/S0956713518302172 (accessed on 27 January 2019).
- Chaibenjawong, P.; Foster, S.J. Desiccation tolerance in Staphylococcus aureus. Arch. Microbiol. 2010, 193, 125–135. Available online: https://link.springer.com/article/10.1007%2Fs00203-010-0653-x (accessed on 27 January 2019). [CrossRef]
- Fuster-Valls, N.; Hernández-Herrero, M.; Marín-de-Mateo, M.; Rodríguez-Jerez, J.J. Effect of different environmental conditions on the bacteria survival on stainless steel surfaces. Food Control 2008, 19, 308–314. Available online: https://www.sciencedirect.com/science/article/pii/S0956713507000795 (accessed on 27 January 2019). [CrossRef]
- Neely, A.N.; Maley, M.P. Survival of enterococci and staphylococci on hospital fabrics and plastic. J. Clin. Microbiol. 2000, 38, 724–726. Available online: https://www.ncbi.nlm.nih.gov/pmc/articles/PMC86187/ (accessed on 27 January 2019).
- Humphrey, T.J.; Martin, K.W.; Whitehead, A. Contamination of hands and work surfaces with Salmonella enteritidis PT4 during the preparation of egg dishes. Epidemiol. Infect. 1994, 113, 403–409. Available online: https://www.ncbi.nlm.nih.gov/pmc/articles/PMC2271315/ (accessed on 27 January 2019). [CrossRef] [PubMed]
- Olaniyan, L.W.B.; Mkwetshana, N.; Okoh, A.I. Triclosan in water, implications for human and environmental health. SpringerpPlus 2016, 5, 1639–1656. Available online: https://springerplus.springeropen.com/articles/10.1186/s40064-016-3287-x (accessed on 27 January 2019). [CrossRef] [PubMed]
- Yueh, M.-F.; Tukey, R.H. Triclosan: A widespread environmental toxicant with many biological effects. Annu. Rev. Pharmacol. Toxicol. 2016, 56, 251–272. Available online: https://www.annualreviews.org/doi/abs/10.1146/annurev-pharmtox-010715-103417?rfr_dat=cr_pub%3Dpubmed&url_ver=Z39.88-2003&rfr_id=ori%3Arid%3Acrossref.org&journalCode=pharmtox (accessed on 27 January 2019). [CrossRef]
- Wang, C.-F.; Tian, Y. Reproductive endocrine-disrupting effects of triclosan: Population exposure, present evidence and potential mechanisms. Environ. Pollut. 2015, 206, 195–201. Available online: https://www.ncbi.nlm.nih.gov/pubmed/26184583 (accessed on 11 March 2019). [CrossRef] [PubMed]
- Greenhalgh, R.; Dempsey-Hibbert, N.C.; Whitehead, K.A. Antimicrobial strategies to reduce polymer biomaterial infections and their economic implications and considerations. Int. Biodeter. Biodegr. 2019, 136, 1–14. Available online: https://www.sciencedirect.com/science/article/pii/S0964830518308345#! (accessed on 11 March 2019). [CrossRef]
- Juric, A.; Singh, K.; Hu, X.F.; Chan, H.M. Exposure to triclosan among the Canadian population: Results of the Canadian health measures survey (2009–2013). Environ. Int. 2019, 123, 29–38. Available online: https://www.ncbi.nlm.nih.gov/pubmed/30485825 (accessed on 11 March 2019). [CrossRef] [PubMed]
- Goodman, M.; Naiman, D.Q.; LaKind, J.S. Systematic review of the literature on triclosan and health outcomes in humans. Crit. Rev. Toxicol. 2017, 48, 1–51. Available online: https://www.ncbi.nlm.nih.gov/pubmed/28741979 (accessed on 11 March 2019). [CrossRef] [PubMed]
- Zineb, K.; Kerim, N.T.K.J.; Claire, B.; Tan-Sothéa, O.; Amel, H.-B.; Rachida, Z. Synthesis, characterization and biological evaluation of triclosan grafted onto cellulosic fibers. Fibers Polym. 2018, 19, 1820–1827. Available online: https://www.springerprofessional.de/en/synthesis-characterization-and-biological-evaluation-of-triclosa/16168674 (accessed on 11 March 2019). [CrossRef]
- U.S. Food and Drug Administration. FDA Issues Final Rule on Safety and Effectiveness of Antibacterial Soaps. 2016. Available online: https://www.fda.gov/newsevents/newsroom/pressannouncements/ucm517478.htm (accessed on 11 March 2019).
- Carey, D.E.; McNamara, P.J. The impact of triclosan on the spread of antibiotic resistance in the environment. Front. Microbiol. 2015, 5, 1–11. Available online: https://www.frontiersin.org/articles/10.3389/fmicb.2014.00780/full (accessed on 27 January 2019). [CrossRef]
- Khan, R.; Roy, N.; Choi, K.; Lee, S.-W. Distribution of triclosan-resistant genes in major pathogenic microorganisms revealed by metagenome and genome-wide analysis. PLoS ONE 2018, 13, e0192277. Available online: https://journals.plos.org/plosone/article?id=10.1371/journal.pone.0192277 (accessed on 27 January 2019). [CrossRef]
- Dann, A.B.; Hontela, A. Triclosan: Environmental exposure, toxicity and mechanisms of action. J. Appl. Toxicol. 2010, 31, 285–311. Available online: https://onlinelibrary.wiley.com/doi/abs/10.1002/jat.1660 (accessed on 26 January 2019). [CrossRef] [PubMed]
- Carmosini, N.; Grandstrand, S.; King-Heiden, T.C. Developmental toxicity of triclosan in the presence of dissolved organic carbon: Moving beyond standard acute toxicity assays to understand ecotoxicological risk. Zebrafish 2016, 13, 424–431. Available online: https://www.liebertpub.com/doi/full/10.1089/zeb.2015.1220 (accessed on 27 January 2019). [CrossRef] [PubMed]
- Huang, C.-L.; Abass, O.K.; Yu, C.-P. Triclosan: A review on systematic risk assessment and control from the perspective of substance flow analysis. Sci. Total Environ. 2016, 566–567, 771–785. Available online: https://www.sciencedirect.com/science/article/pii/S0048969716309081?via%3Dihub (accessed on 27 January 2019). [CrossRef] [PubMed]
- Bhargava, H.N.; Leonard, P.A. Triclosan: Applications and safety. Am. J. Infect. Control 1996, 24, 209–218. Available online: https://www.ajicjournal.org/article/S0196-6553(96)90017-6/pdf (accessed on 27 January 2019). [CrossRef]

| Sample | Triclosan (ppm *) | Dry Condition | Humidity Condition |
|---|---|---|---|
| Id1 | 0 | 0.74 ± 0.13 a,A | 0.34 ± 0.06 a,B |
| Id2 | 400 | 0.99 ± 0.42 a,A | 0.19 ± 0.02 a,B |
| Id3 | 500 | 0.68 ± 0.16 a,A | 0.25 ± 0.03 a,B |
| Id4 | 650 | 1.02 ± 0.16 a,A | 0.16 ± 0.01 a,B |
| Id5 | 850 | 1.17 ± 0.39 a,A | 0.20 ± 0.02 a,B |
| Sample | Triclosan | Dry Condition | Humidity Condition | ||||
|---|---|---|---|---|---|---|---|
| (ppm *) | Inhibition Size (cm) | Microscopy (Cells/cm2) | Inhibition Size (cm) | Microscopy (Cells/cm2) | |||
| Live | Dead/Injured | Live | Dead/Injured | ||||
| Id1 | 0 | - | 1.63 × 105 | 2.58 × 104 a | - | 1.47 × 106 a | 2.83 × 103 a |
| Id2 | 400 | 0.36 ± 0.05 c,B | ND | 3.11 × 101 b | 0.48 ± 0.07 c,A | 0.58 × 101 b | 1.95 × 101 b |
| Id3 | 500 | 0.61 ± 0.08 b,A | ND | 2.08 × 102 b | 0.56 ± 0.05 b,A | 2.56 × 101 b | 0.11 × 101 b |
| Id4 | 650 | 0.63 ± 0.07 b,A | ND | 1.76 × 102 b | 0.64 ± 0.07 b,A | ND | ND |
| Id5 | 850 | 0.88 ± 0.05 a,A | ND | 8.42 × 101 b | 0.95 ± 0.06 a,A | ND | ND |
© 2019 by the authors. Licensee MDPI, Basel, Switzerland. This article is an open access article distributed under the terms and conditions of the Creative Commons Attribution (CC BY) license (http://creativecommons.org/licenses/by/4.0/).
Share and Cite
Ríos-Castillo, A.G.; Ripolles-Avila, C.; Rodríguez-Jerez, J.J. The Effects of Dry, Humid and Wear Conditions on the Antimicrobial Efficiency of Triclosan-Containing Surfaces. Appl. Sci. 2019, 9, 1717. https://doi.org/10.3390/app9081717
Ríos-Castillo AG, Ripolles-Avila C, Rodríguez-Jerez JJ. The Effects of Dry, Humid and Wear Conditions on the Antimicrobial Efficiency of Triclosan-Containing Surfaces. Applied Sciences. 2019; 9(8):1717. https://doi.org/10.3390/app9081717
Chicago/Turabian StyleRíos-Castillo, Abel Guillermo, Carolina Ripolles-Avila, and José Juan Rodríguez-Jerez. 2019. "The Effects of Dry, Humid and Wear Conditions on the Antimicrobial Efficiency of Triclosan-Containing Surfaces" Applied Sciences 9, no. 8: 1717. https://doi.org/10.3390/app9081717
APA StyleRíos-Castillo, A. G., Ripolles-Avila, C., & Rodríguez-Jerez, J. J. (2019). The Effects of Dry, Humid and Wear Conditions on the Antimicrobial Efficiency of Triclosan-Containing Surfaces. Applied Sciences, 9(8), 1717. https://doi.org/10.3390/app9081717

